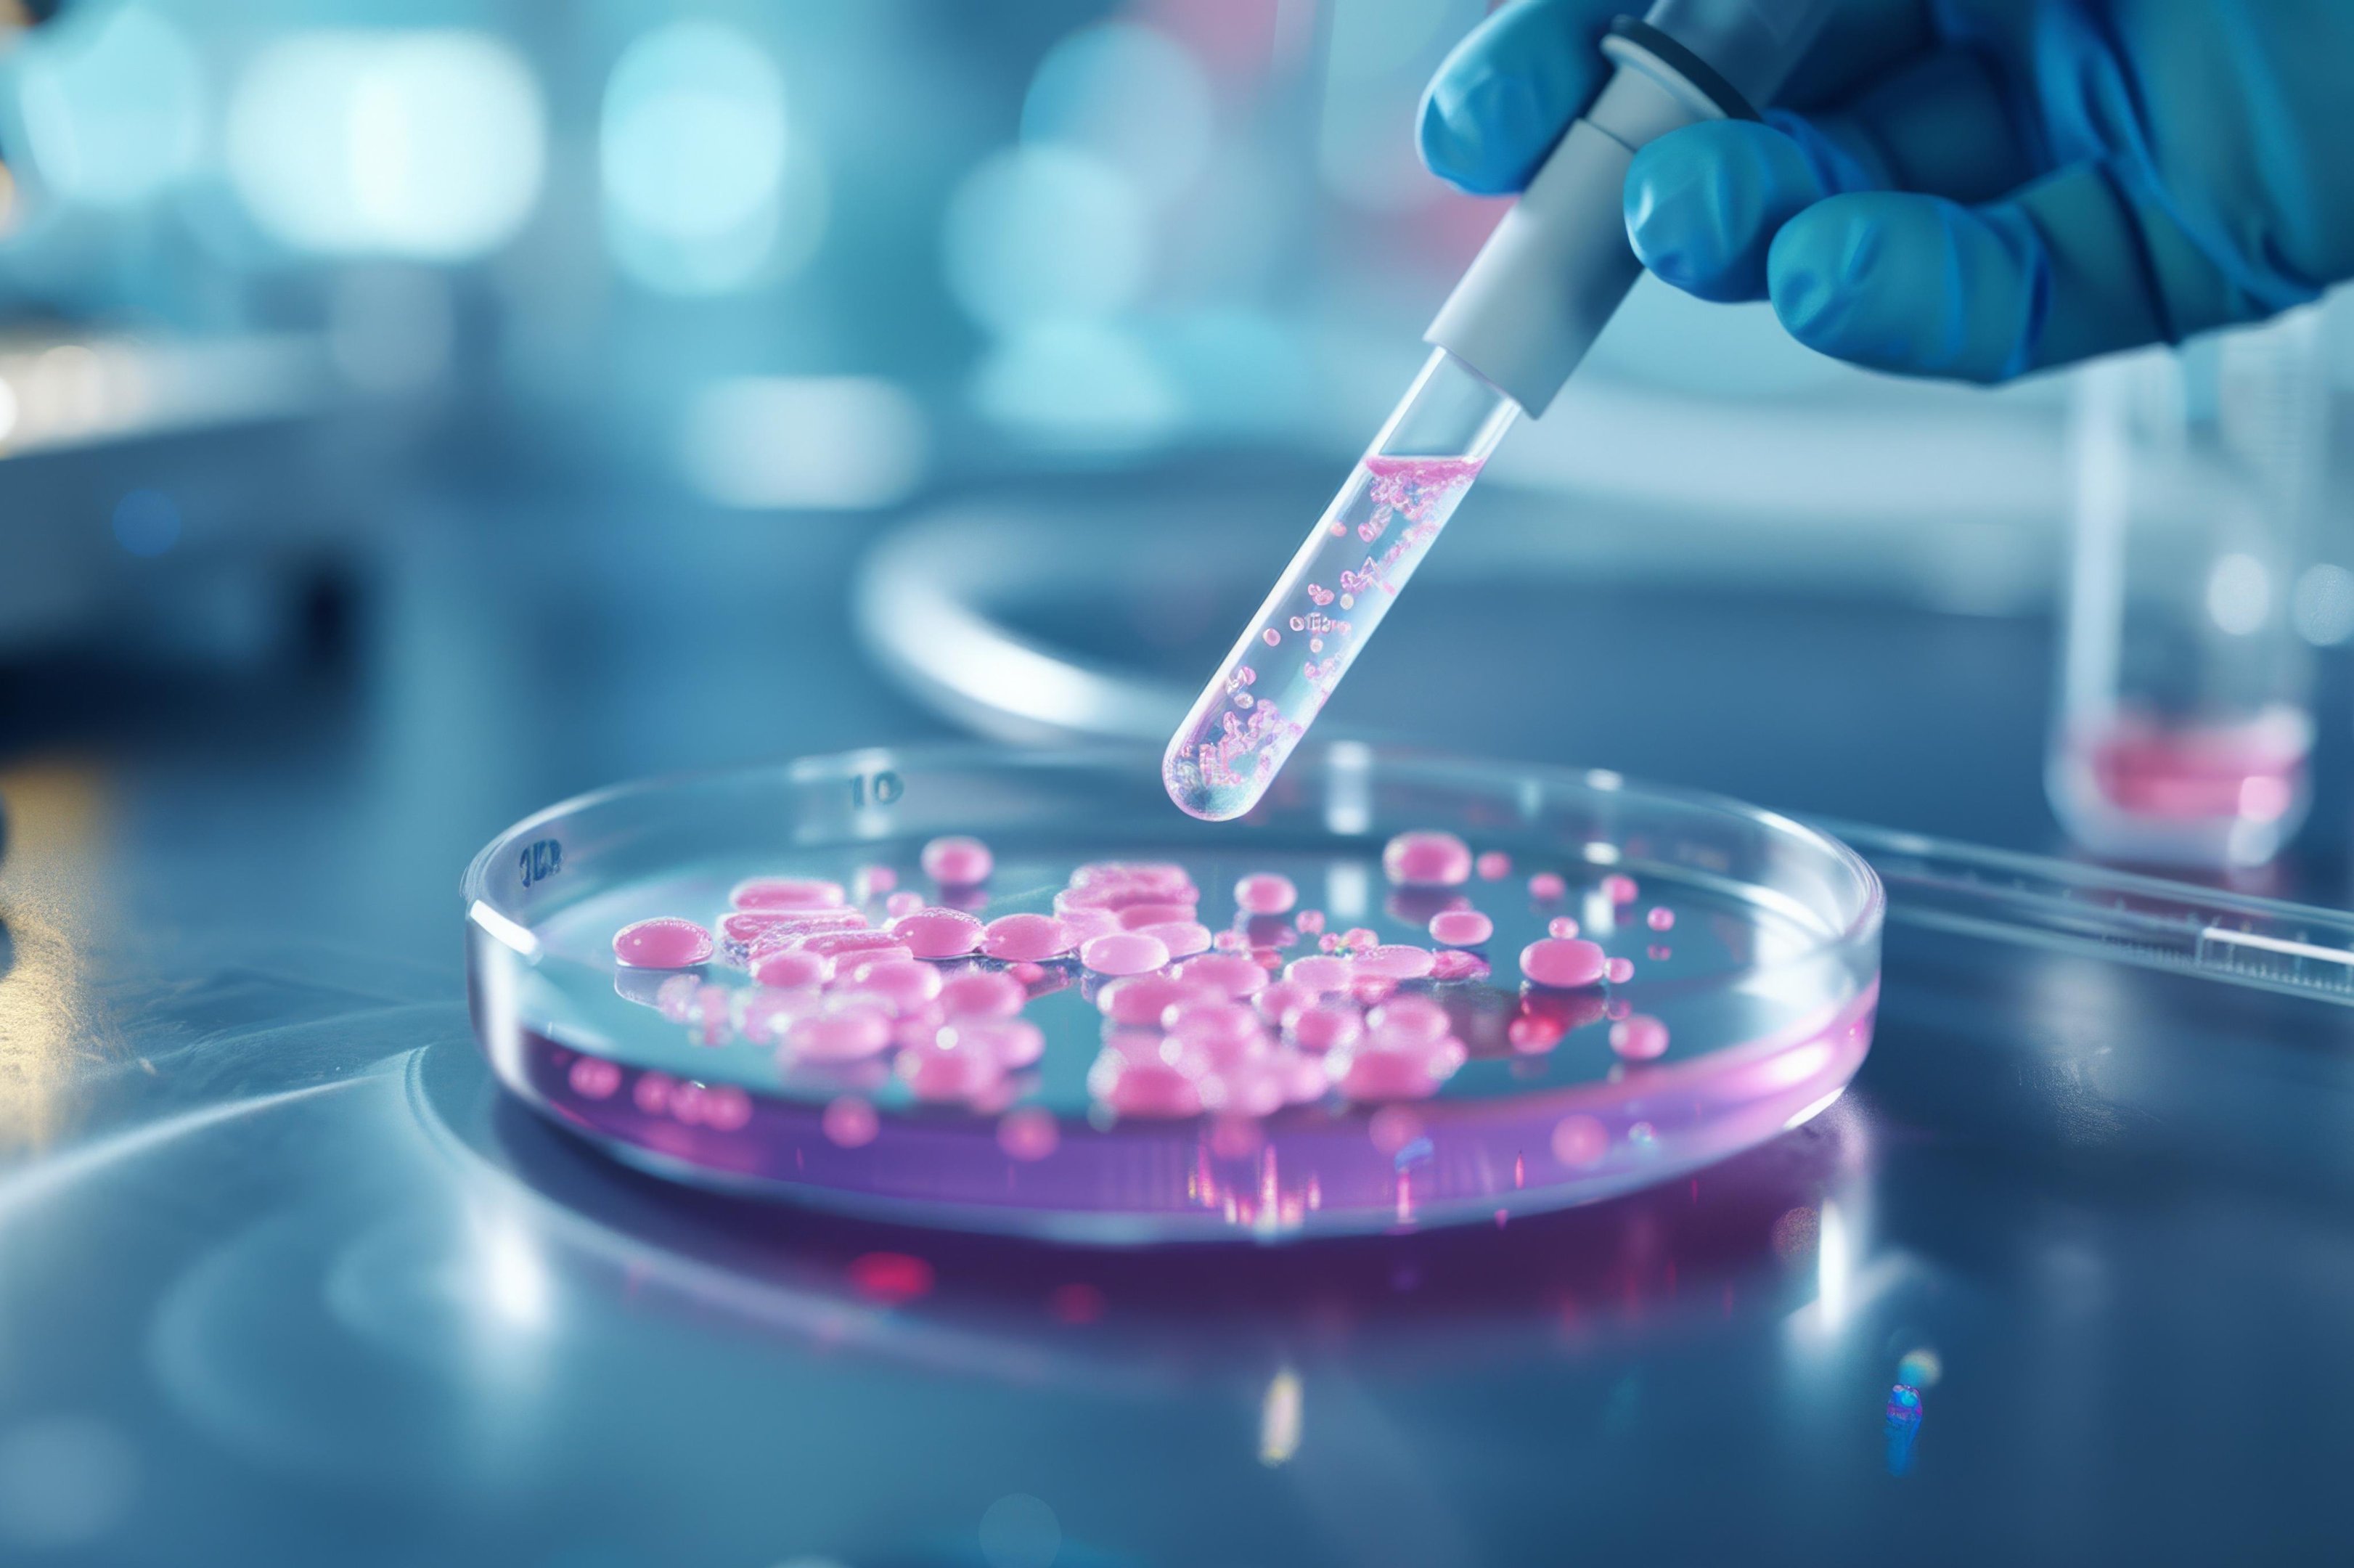
O que se sabe sobre furto de v&iacute;rus em universidade de SP e se h&aacute; risco de contamina&ccedil;&atilde;o

Petróleo tem alta forte e pressiona dólar e bolsa no Brasil
O principal índice da bolsa de valores brasileira (B3), o Ibovespa, também sentiu o aumento de incertezas e caiu 1,45%, para 182,7 mil pontos. O petróleo avançou cerca de 5% e chegou a ficar perto do patamar de US$ 110 durante o dia. Às 17h, a cotação do barril do tipo brent, referência internacional, estava em US$ 107,51, maior nível em cerca de uma semana. No Brasil, o Índice Nacional de Preços ao Consumidor Amplo-15 (IPCA-15), considerada a prévia da inflação oficial do país, subiu 0,44% em março de 2026. Isso elevou o nível de risco no mercado local e empurrou para baixo o desempenho dos ativos brasileiros.
Source: Zero Hora March 26, 2026 20:24 UTC